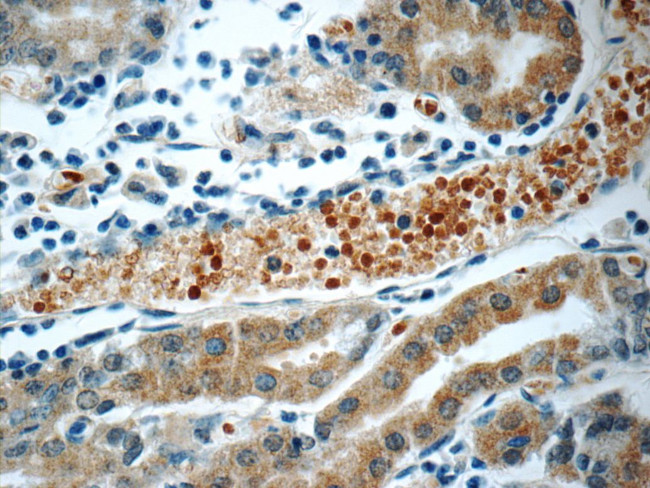
SMAP1 Antibody in Immunohistochemistry (Paraffin) (IHC (P))

Search
Proteintech
SMAP1 Polyclonal Antibody
{{$productOrderCtrl.translations['antibody.pdp.commerceCard.promotion.promotions']}}
{{$productOrderCtrl.translations['antibody.pdp.commerceCard.promotion.viewpromo']}}
{{$productOrderCtrl.translations['antibody.pdp.commerceCard.promotion.promocode']}}: {{promo.promoCode}} {{promo.promoTitle}} {{promo.promoDescription}}. {{$productOrderCtrl.translations['antibody.pdp.commerceCard.promotion.learnmore']}}
产品信息
12799-1-AP
种属反应
宿主/亚型
分类
类型
抗原
偶联物
形式
浓度
规格
纯化类型
保存液
内含物
保存条件
运输条件
产品详细信息
This antibody is a rabbit polyclonal antibody raised against residues near the N terminus of human SMAP1.
Immunogen sequence: MATRSCREK AQKLNEQHQL ILSKLLREED NKYCADCEAK GPRWASWNIG VFICIRCAGI HRNLGVHISR VKSVNLDQWT AEQIQCMQDM GNTKARLLYE ANLPENFRRP QTDQAVEFFI RDKYEKKKYY DKNAIAITNI SSSDAPLQPL VSSPSLQAAV DKNKLEKEKE KKKEEKKREK EPEKPAKPLT AEKLQKKDQQ LEPKKSTSPK KAAEPTVDLL GLDGPAVAPV TNGNTTVPPL NDDLDIFGPM ISNPLPATVM PPAQGTPSAP AAATLSTVTS GDLDLFTE (1-287 aa encoded by BC036123)
靶标信息
The protein encoded by this gene is similar to the mouse stromal membrane-associated protein-1. This similarity suggests that this human gene product is also a type II membrane glycoprotein involved in the erythropoietic stimulatory activity of stromal cells. Alternate splicing results in multiple transcript variants encoding different isoforms.
仅用于科研。不用于诊断过程。未经明确授权不得转售。
篇参考文献 (0)
生物信息学
蛋白别名: small ArfGAP 1; stromal membrane-associated GTPase-activating protein 1; Stromal membrane-associated protein 1; unnamed protein product
基因别名: 1700056O10Rik; 4921514B13Rik; 4921525H11Rik; AI462175; SMAP-1; SMAP1
UniProt ID: (Human) Q8IYB5, (Mouse) Q91VZ6
Entrez Gene ID: (Human) 60682, (Mouse) 98366, (Rat) 684800